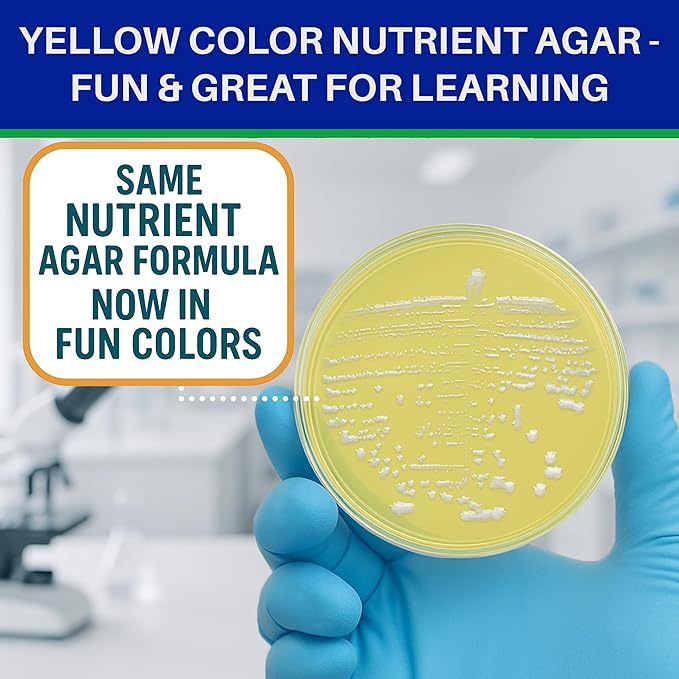
Evviva Sciences Nutrient Agar Petri Dishes Science Project Kit, Pre-Poured Agar Plates for Science Experiments, with Experiment eBook (Yellow)
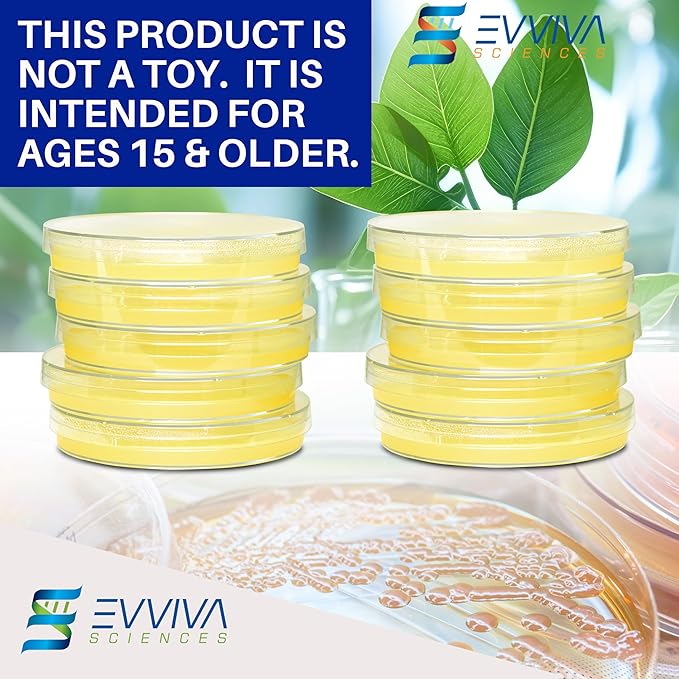
Evviva Sciences Nutrient Agar Petri Dishes Science Project Kit, Pre-Poured Agar Plates for Science Experiments, with Experiment eBook (Yellow)
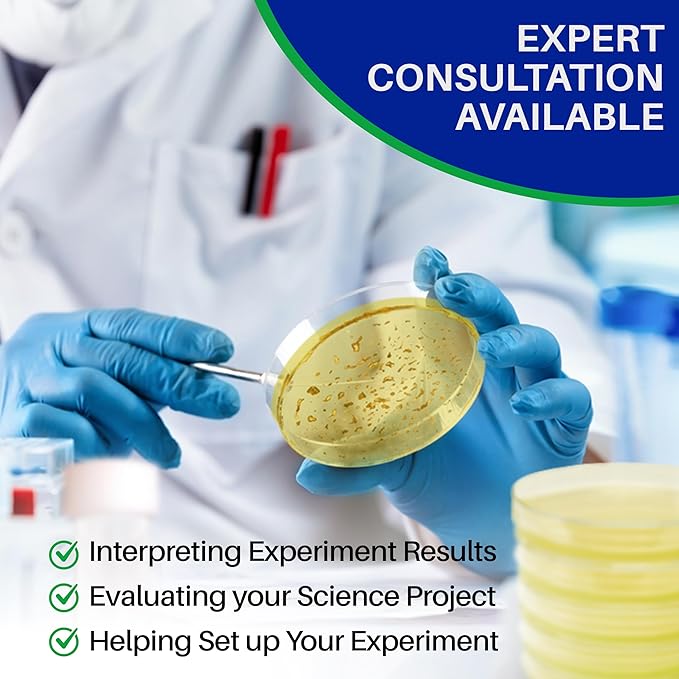
Evviva Sciences Nutrient Agar Petri Dishes Science Project Kit, Pre-Poured Agar Plates for Science Experiments, with Experiment eBook (Yellow)

1
/
의
9
EVVIVASCIENCES
Evviva Sciences Nutrient Agar Petri Dishes Science Project Kit, Pre-Poured Agar Plates for Science Experiments, with Experiment eBook (Yellow)
Evviva Sciences Nutrient Agar Petri Dishes Science Project Kit, Pre-Poured Agar Plates for Science Experiments, with Experiment eBook (Yellow)
정가
$34.49 USD
정가
할인가
$34.49 USD
수량
픽업 사용 가능 여부를 로드할 수 없습니다.
About This
- THE COMPLETE SCIENCE KIT: Start your science experiment journey with our kit, complete with 10 pre-poured agar plates, 10 cotton tipped sticks, simple-to-follow instructions, and an informative science experiment e-book project guide.
- RELIABLE & SECURE: Experience the height of science with our kit. These agar plates include a thick agar layer, and they are ready to use for your experiment. The customized packaging are more durable than conventional solutions. This kit was created for educational purposes for ages 15 and older.
- CONVENIENTLY PRE-POURED FOR EASY USE: Our pre-poured, ready-to-use nutrient agar petri dishes eliminates the need for technical agar melting and pouring. Our skillfully concocted plates facilitates proper agar consistency and thickness.
- THE EXPERIMENT EBOOK: Get creative and think of thrilling ideas and experiment with our science kit that includes an exciting experiment ebook. The eBook is filled with simple experiments that come with clear step-by-step instructions to help you succeed!
- WE VALUE CUSTOMER SATISFACTION: We believe that you will enjoy your science fair project kit and would even suggest it to your acquaintances. However, if you are not entirely satisfied with it, we will happily provide a complete refund.
Share